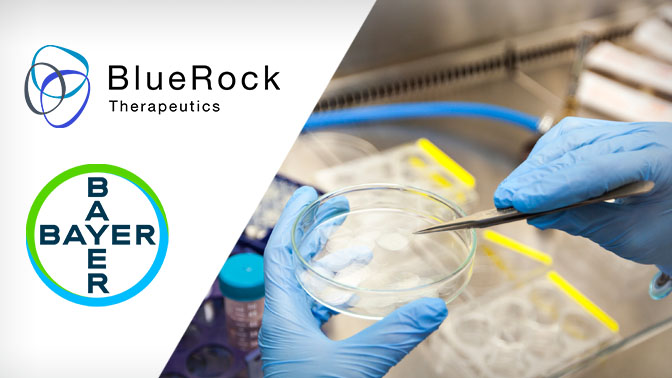

Bayer Pharmaceuticals acquired BlueRock therapeutics in 2019 for $600 million. Bayer, which co-founded BlueRock in a 2016 joint venture with Versant Ventures, will now gain the remaining 59.2% ownership for an upfront payment of approximately $240 million, with an additional $360 million contingent on meeting specific development milestones. BlueRock specializes in induced pluripotent stem cells (iPSCs), which are created by reprogramming adult cells to function like embryonic stem cells, thereby regenerating damaged or diseased tissue in patients. At the time of the deal, Stefan Oelrich, a Member of the Board of Management at Bayer AG, had this to say:
“This acquisition marks a major milestone on our path towards a leading position in cell therapy,…
“In line with our strategy to ramp up our investments in technologies with breakthrough innovation potential, we have decided to build our cell therapy pipeline based on BlueRock Therapeutics’ industry-leading iPSC platform. Ultimately, we are joining forces to deliver new treatment options for medical needs that are still unmet today.”
Through this acquisition, Bayer gained full ownership of BlueRock Therapeutics’ CELL+GENE™ platform, including its extensive intellectual property portfolio and proprietary technologies in iPSC development, gene engineering, and cell differentiation. While BlueRock currently focuses on specific therapeutic areas, the platform also offers the potential for expansion into additional disease targets. To maintain its innovative and entrepreneurial spirit, BlueRock has continued to operate as an independent entity under an arm’s-length structure. Parkinson’s disease is the most rapidly increasing neurodegenerative disorder in terms of prevalence, disability, and mortality. Its hallmark and most debilitating symptom is the progressive decline in motor control. Stem cell therapy offers the potential to re-innervate the brain and reverse neurodegeneration, with the possibility of restoring motor function in over seven million individuals affected by Parkinson’s disease worldwide.

The cell therapy for Parkinson’s
The investigational cell therapy bemdaneprocel (BRT-DA01) is entering Phase III of the clinical trials for the treatment of Parkinson’s disease in Q1 of 2025. BRT-DA01 is categorized under the classification of Regenerative Medicine Advanced Therapy (RMAT). The FDA classifies a drug as RMAT if it is:
- A cell therapy, therapeutics tissue engineering product, human cell and tissue product, or any combination product using such therapies or products
- The drug is intended to treat, modify, reverse, or cure a serious or life-threatening disease or condition
- Preliminary clinical evidence indicates that the drug has the potential to address unmet medical needs for such disease or condition
BRT-DA01 also received the fast-track designation from the FDA in 2021. The Fast Track is a regulatory framework designed to accelerate the development and evaluation of new drugs or biologics targeting severe conditions, especially those with unmet medical needs. It facilitates more frequent interactions with the FDA, allows for rolling submissions of application sections, and can be given Accelerated Approval or Priority Review.

BRT-DA01’s Mechanism of Action
Bemdaneprocel (BRT-DA01) works by replacing the dopamine-producing neurons lost in Parkinson’s disease. Derived from pluripotent stem cells, the dopaminergic neuron precursors—originally human embryonic stem cells—mature into functional dopamine neurons after implantation. Through a surgical procedure, these precursors are implanted into the brain of a person with Parkinson’s disease, where they have the potential to rebuild damaged neural networks and restore both motor and non-motor functions.
CLINICAL Overview
In Phase I, the drug was well tolerated by 12 participants, with no adverse events reported 24 months post-surgery. There was also promising data showing improvements in motor function at 24 months post-surgery. Building on prior findings, exPDite-2 (Phase III) is a double-blind study designed to evaluate the efficacy, safety, and overall effects of bemdaneprocel in comparison to a sham surgery control. The trial aims to enroll approximately 102 individuals with moderate Parkinson’s disease. This trial was approved by the FDA after BRT-DA01 was given the RMAT designation in May 2024 and with the Fast Track designation granted in 2021. The Phase III primary endpoint will be to assess the change from baseline to week 78 in Parkinson’s Disease diary measure of ON-time without troublesome dyskinesia, as recorded in patient diaries and adjusted for a 16-hour waking day. Secondary endpoints will include objective assessments of motor function, evaluations of safety and tolerability, as well as tools measuring daily living activities and overall quality of life.
Parkinson’s disease (PD) is a progressive neurodegenerative disorder that severely affects daily functioning. It is caused by the gradual loss of dopamine-producing neurons in the brain, resulting in worsening motor symptoms, including tremors, muscle stiffness, and slowed movement. Patients also experience non-motor symptoms, including fatigue, cognitive decline, and depression. These symptoms intensify over time, making routine tasks increasingly difficult. Over the past 25 years, the global prevalence of PD has doubled, with more than 10 million individuals currently affected—making it the second most common neurodegenerative disease and the leading movement disorder. There is currently no cure, and existing treatments do not comprehensively address the range of symptoms, underscoring the urgent need for new therapeutic approaches. If proven effective, this therapy, co-developed by Bayer and BlueRock, could represent the first curative treatment for Parkinson’s disease and the first to implant engineered pluripotent stem cells into the human brain successfully.
Leave a comment